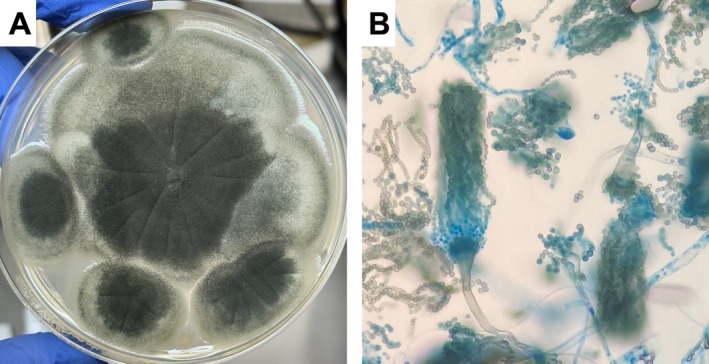

非手术指征支气管镜下曲菌瘤切除1例。
IF 0.8
Q4 RESPIRATORY SYSTEM
引用次数: 0
摘要
一位76岁的男性被诊断为左上肺叶曲菌瘤。由于高龄和结肠癌复发,手术不是一个选择。用活检钳切除曲菌瘤。然后,病变和痰液减少。可以考虑支气管镜切除,特别是对于没有手术指征的患者。本文章由计算机程序翻译,如有差异,请以英文原文为准。

A Case of Bronchoscopic Removal of Aspergilloma in Patients With Non-Surgical Indications.
A 76-year-old man was diagnosed with aspergilloma in the left upper lobe. Due to advanced age and recurring colon cancer, surgery was not an option. The aspergilloma was removed with biopsy forceps. Then, the lesion and sputum were decreased. Bronchoscopic removal can be considered, particularly for patients without surgical indications.
求助全文
通过发布文献求助,成功后即可免费获取论文全文。
去求助
来源期刊

Respirology Case Reports
RESPIRATORY SYSTEM-
CiteScore
1.40
自引率
0.00%
发文量
178
审稿时长
8 weeks
期刊介绍:
Respirology Case Reports is an open-access online journal dedicated to the publication of original clinical case reports, case series, clinical images and clinical videos in all fields of respiratory medicine. The Journal encourages the international exchange between clinicians and researchers of experiences in diagnosing and treating uncommon diseases or diseases with unusual presentations. All manuscripts are peer-reviewed through a streamlined process that aims at providing a rapid turnaround time from submission to publication.
 求助内容:
求助内容: 应助结果提醒方式:
应助结果提醒方式:


